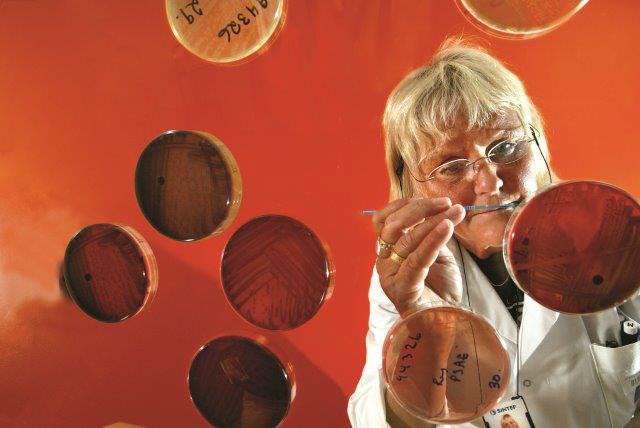
Scientists raise alarm over today’s measures against Legionellosis

Artificial heart with Norwegian sensor
France is going to test an artificial heart on patients. The heart will contain a Norwegian pressure sensor.

France is going to test an artificial heart on patients. The heart will contain a Norwegian pressure sensor.
The robot effortlessly picks up one castor after another from the pile in the box and puts them into the channel. No matter how the wheels are lying, the robot manages to get an exact grip.

Batteries as big as houses could become an important component of our electricity supply in the future – enabling us to exploit renewable energy that at present literally just flies past us.

A handbook has been made to summarize the STOP project and the project results. It easily explains torrefaction and what can be achieved by torrefying biomass.

Of all the CO2 that is produced in the Nordic countries, the cheapest to deal with is what is produced together with natural gas from offshore gas-fields.

While Europe invests in wind energy, Norwegian hydropower offers the key to stable electricity supplies.

Batteries as big as houses could become an important component of our electricity supply in the future – enabling us to exploit renewable energy that at present literally just flies past us.

A researcher is making gentle, gymnastic hand movements in front of his tablet computer. Why?

Of all the CO2 that is produced in the Nordic countries, the cheapest to deal with is what is produced together with natural gas from offshore gas-fields.

The European project NANOMED2020s core mission is to federate the nanomedicine community. The projects newly released Map provides thorough insights into the existing nanomedicine community by introducing on a single chart all the ecosystem‘s actors...

While Europe invests in wind energy, Norwegian hydropower offers the key to stable electricity supplies.

Long pipelines crammed with electronics are being tested in the waters of Orkanger harbour. They are the first in the world able to report their technical condition to personnel onshore

Long pipelines crammed with electronics are being tested in the waters of Orkanger harbour. They are the first in the world able to report their technical condition to personnel onshore.

Long pipelines crammed with electronics are being tested in the waters of Orkanger harbour. They are the first in the world able to report their technical condition to personnel onshore.

A new Norwegian fishing rod is about to be launched onto the world market. The inventor calls it fly fishing’s equivalent of carving skis

Aluminium components make vehicles lighter, which reduces fuel consumption. If a Norwegian project is successful, manufacturing them will soon also be less energy-intensive.

Flat organisations confuse foreign workers, and this in turn reduces Norwegian industrial efficiency.

For the first time, a car manufacturer has opened the way for Norwegian research scientists to log data directly from the innermost systems of cars. If this practice becomes widespread, the transport industry will have a tool enabling vital decision...

Ex-drug and alcohol abusers who have completed their treatment need a simple support system and daily motivation. Now they are getting both – in a handy pocket format.

The Research Council of Norway recently awarded IFE and SINTEF 40 million NOK to upgrade their multiphase flow laboratories. This marks the beginning of a new era within multiphase flow research in Norway and a re-vitalized collaboration between IFE...

Ex-drug and alcohol abusers who have completed their treatment need a simple support system and daily motivation. Now they are getting both – in a handy pocket format.

SINTEF takes an extremely serious view of the forgery of a MARINTEK report, and has reported the incident to the police as a case of document forgery.

According to the textbooks, both high doses of chlorine and hot water are lethal to legionella bacteria. But now Norwegian scientists are sounding the alarm that the bacteria can survive these treatments, by hiding in amoebae.
According to the textbooks, both high doses of chlorine and hot water are lethal to legionella bacteria. But now Norwegian scientists are sounding the alarm that the bacteria can survive these treatments, by hiding in amoebae.

A new on-board system enables fishermen to keep track of their own and other vessels’ fishing gear.

MARINTEK has just received NOK 50 million from the Research Council of Norway’s Large-scale Infrastructure Fund. The Institute won in fact 10 per cent of the total of MNOK 500 made available.

Aluminium components make vehicles lighter, which reduces fuel consumption. If a Norwegian project is successful, manufacturing them will soon also be less energy-intensive.

A new Norwegian fishing rod is about to be launched onto the world market. The inventor calls it fly fishing’s equivalent of carving skis.

Norwegian research shows that it is perfectly possible for rivers to produce more salmon and electricity at the same time: a new environmental handbook shows the way.

A large touch-screen at the Dønski Safety Unit in Bærum is the engine driving a new information system that facilitates information flow and reduces wasted time. This is benefiting the municipality's staff and its elderly residents.

Researchers will spend the next two years gathering meteorological data from Svalbard in the north to Nittedal in the south. The aim is to find out how much satellite signals are adversely affected by rain, atmospheric pressure and other...

Two years ago Kongsberg Oil & Gas Technologies AS (KOGT) introduced the steady-state and transient multiphase flow simulator LedaFlow® to the oil and gas industry. Now the version LedaFlow 1.4 is released with improved models and numerics well suited...

A flag waving in the wind can illustrate what we call "air-solids interaction". When the wind hits the top of the flagpole the flag dances to the wind's rhythms, often in complex ways. And as we all know: it takes two to tango. The air-flow is also...

Just think if your surgeon could tell you whether an operation had been successful, even before the scalpel touched your skin. Research scientist Sigrid K. Dahl from SINTEF Materials and Chemistry means to use simulation models to make that dream a...

The ESA wants its operations on other planets to have greater mobility and manoeuvrability. SINTEF researchers are looking into whether snake robots could be the answer.

Thomas Langø takes over as Research Director for the Department of Medical Technology after Toril N. Hernes, who goes to NTNU as head of the Department of Circulation and Medical Imaging at the Medical Faculty.

Patients can use tablet computers to report their daily condition. Hospitals can pick up early symptoms, take action and thereby reduce admissions

Recently, research scientists heralded "a big step for mankind" – in a new shop in Trondheim, Norway which they believe will use 30 per cent less energy than other Norwegian grocery stores.

Instability in power grids can have serious consequences. A new publication from SINTEF Academic Press describes a mathematical method to help prevent such instability.

As part of the FHF funded project "Human factors and escapes from salmon farms", SINTEF Fisheries and Aquaculture arranged an international workshop associated with Aqua Nor 2013. Representatives from Scotland, Ireland, USA, Canada, Australia, New...

Backed up by science, a Norwegian start-up launches “fishing luck in a tube”.

Dementia patients who are kept active in their fields of interest appear to experience improved quality of life and better health. Research will now reveal whether this is really true.

They are the world leader in long, slim tools for manufacturing advanced aircraft components and offshore oil valves. Now the company is to fit sensors to its tools to prevent valuable materials being wasted.

Backed up by science, a Norwegian start-up launches “fishing luck in a tube”.

A workshop titled “New technology for the Nordic fishing fleet: Fishing gear and effective catch handling” will be held in Reykjavik, Iceland, on October 1st & 2nd 2013.

This ship makes it easier to find one’s sea legs, thanks to opposing waves created in specially-designed tanks fitted in the hull. The ship will house personnel working on offshore installations, and is optimized to provide the best possible comfort...

Our vast country offers plenty of natural resources, both natural gas and iron ore may very well form a solid basis for sustainable industrial establishments. Today, it is possible to produce iron and other metals, with a much lower CO2 emissions and...

SINTEF has established a new research centre for multiphase flow technology. The centre strengthens an already world-leading research group. The new Multiphase Flow Centre gathers researchers and laboratories from several parts of SINTEF into a...

Norwegian researchers have developed a hip protector in a sporty design. Its looks are intended to appeal to the older people of today – who are quite particular about what they will wear.

Norwegian researchers have developed a hip protector in a sporty design. Its looks are intended to appeal to the older people of today – who are quite particular about what they will wear.

SINTEF will play a key role in a European Union project that aims to ensure that captured CO2 can be transported safely and cost-effectively by pipeline from the capture site to the storage site.

Norwegian scientists want to develop greener and more vigorous batteries, using inexpensive raw materials that are plentiful in Norway.

Norwegian scientists want to develop greener and more vigorous batteries, using inexpensive raw materials that are plentiful in Norway.

SINTEF Energy Research will play a key role in a European Union project that aims to ensure that captured CO2 can be transported safely and cost-effectively by pipeline from the capture site to the storage site.

A beer can, cars and burned-out tea candles represents only a part of what brings new life to aluminum scrap. Aluminum is a limited resource, but luckily the aluminum has longevity and ability to reuse the metal is good.

"Computational tools help identify the effects of fluids slamming against a structure". In "Modelling industrial processes: No joshing about sloshing" from 2011, SINTEF Materials and Chemistry's scientist Paal Skjetne sketches the challenges we are...

Research scientists have developed a new method for stabilising areas with difficult soil mechanics. The concept is based on blowing expanded clay (Leca) spheres into enormous “sausage skins” made from geotextiles.

When hospitals group patient rooms into small clusters, nurses have more time for their patients. But the design of these ‘bed clusters’ is important.

Research scientists believe it will be possible to manufacture a competitive aviation fuel by 2020-2025.

When did you last book a flight? Or buy something online? Was it painless – or did you have a poor user experience?

Drilling an oil well is not what it used to be. The job needs its own special tools, the dexterity of a pilot, and bundles of experience.

A new-born “mole” homes in on small oil reservoirs – an almost untapped source of income.

A sensor developed in Norway gives microphones hyper-acute hearing and a sense of direction.

The innumerable divisions of the bronchi often turn the hunt for tumours in the lungs into a game of chance. But soon, lung specialists will be able to navigate accurately inside the airways by “GPS”.

In Holmestrand, Norway, scrap aluminium gains a new lease of life – via energy-efficient technology, while Europe gets rolled recycled aluminium panels that are tough enough to be used as external cladding for buildings.

The innumerable divisions of the bronchi often turn the hunt for tumours in the lungs into a game of chance. But soon, lung specialists will be able to navigate accurately inside the airways by “GPS”.

In Holmestrand, Norway, scrap aluminium gains a new lease of life – via energy-efficient technology, while Europe gets rolled recycled aluminium panels that are tough enough to be used as external cladding for buildings.

The 1st Ocean Technology Summit took place June 4th 2013, during Nor-Shipping 2013. The conference proved to be a huge success, both in terms of the chosen topics (green shipping and arctic challenges) and the number of participants.

Helping people with chronic liver failure to live longer, better lives.

Is it really possible to get broadband coverage in the Arctic? "Yes, indeed!", say Telenor, the Norwegian Space Centre and the SINTEF company MARINTEK, who are currently looking into how they can make it happen.

SINTEF's South American spin-off, the Brazilian research foundation Instituto SINTEF do Brasil, has brought into harbour its first three contracts worth NOK 28 million (USD 4.8 million).

SINTEF Petroleum Research is proud to announce the immediate availability of the regional petroleum systems/basin modelling study "Western Barents Sea Study 2012 (WBS 2012) – Mesozoic play types: evaluation and uncertainty".

A full 90% of all the data in the world has been generated over the last two years. The internet companies are awash with data that can be grouped and utilised. Is this a good thing?

Tops and branches from tree-felling sites are reborn in the laboratory as compact pellets. However, the energy industry will not act until the price is right.

Tomorrow’s offshore oil will be highly viscous – and it will be a heavy job to bring it ashore. But newly-won knowledge is offering hope for fields that today would have been turned down by the economists.

This is Angel Perez Garcia. He can make a robot move exactly as he wants via the electrodes attached to his head.

Hard times for the shipping companies. Some of the blame lies with ships' officers who are failing to put new procedures into practice.

Hard times for the shipping companies. Some of the blame lies with ships' officers who are failing to put new procedures into practice.

Heavy goods vehicles on Norwegian roads will soon be checked and weighed automatically – while on the road.

Heavy goods vehicles on Norwegian roads will soon be checked and weighed automatically – while on the road.

The Norwegian Petroleum Directorate (NPD) is taking over a collection of 6.6 kilometres of shallow rock cores from the Norwegian continental shelf from SINTEF.
SINTEF has established a research centre for multiphase flow technology. The centre strengthens an already world-leading research group. The new Multiphase Flow Centre includes researchers and laboratories from several parts of SINTEF into a single...

A new-born “mole” homes in on small oil reservoirs – an almost untapped source of income.

Jellyfish populations have exploded in many Norwegian fjords in recent years. For more than ten years the inner Trondheimsfjord ecosystem has been dominated by the big jellyfish Periphylla periphylla. Fishing nets are filled with this species that...

Researchers have recently succeeded in doubling survival rates among lobster larvae under farmed conditions. This could boost populations of a species threatened in the wild.

Researchers aim to make it just as economic to process fish in Norway as to send them to China.

Norway is helping Africa’s youngest oil nation with a prescription for prosperity – and is finding out that learning goes both ways.

Drilling an oil well is not what it used to be. The job needs its own special tools, the dexterity of a pilot, and bundles of experience.

A robot is now being built to help stroke patients with training, motivation and walking

SINTEF, as part of the CCS Leadership Coalition, writes to President of European Commission calling for help getting CCS back on track.

The sport of cross-country skiing has always been preoccupied with its skis and waxing. Research now demonstrates that to shave off those extra hundredths of a second, competitive skiers should pay more attention to their clothing.

SINTEF intends to try and measure the noise generated by individual cars in traffic. This information will form one of several types of data registered at a measurement station.

The sport of cross-country skiing has always been preoccupied with its skis and waxing. Research now demonstrates that to shave off those extra hundredths of a second, competitive skiers should pay more attention to their clothing.

Microalgae are a renewable resource that is central to marine food production, and microalgae should also be considered to a much larger extent in terrestrial production such as in feed for mink or poultry. They are rich in compounds such as protein...

As part of the research project Trygge Spor, more than fifty dementia sufferers have been using GPS for periods varying from several weeks to up to a year. The results show that localisation technology helps achieve an increased sense of security...

As part of the research project Trygge Spor, more than fifty dementia sufferers have been using GPS for periods varying from several weeks to up to a year. The results show that localisation technology helps achieve an increased sense of security...

Nine out of ten Norwegian fish-processing plants have closed, and a great deal of fish leave the country without being processed. However, according to a recent SINTEF report, the Norwegian fish-processing industry can be put on its feet again with...

An abandoned chicken farm in Macedonia has been turned into one of the country’s most modern food factories. Its owner gives two SINTEF researchers much of the credit for the transformation.

A bilateral competence project has opened the door to Japanese expertise in the field of alloy development for the aluminium giant Hydro. “This is an extremely important area for us,” says Trond Furu, a senior advisor in Hydro.

An abandoned chicken farm in Macedonia has been turned into one of the country’s most modern food factories. Its owner gives two SINTEF researchers much of the credit for the transformation.

A coating filled with tiny lubricant capsules could come to the rescue when metal surfaces dry out and friction builds up.